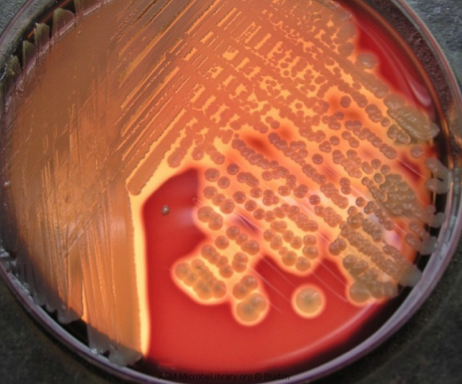
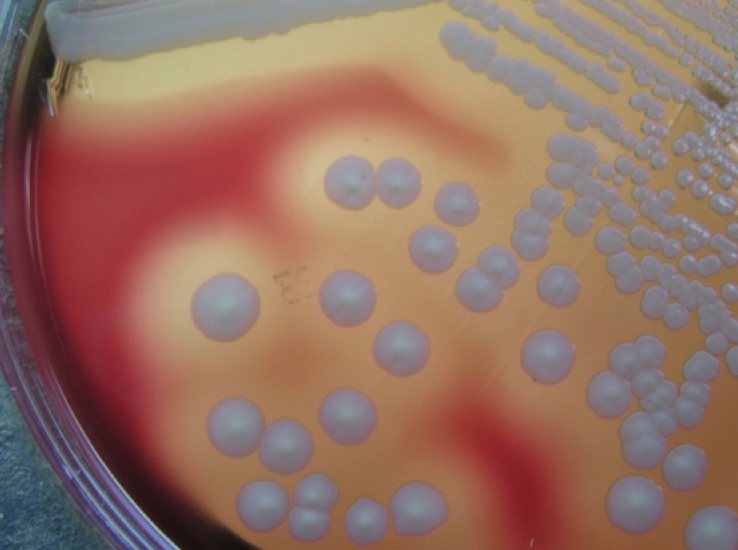

T/F: Staphylococcus is part of the normal flora of the skin in most animals.
True
T/F: Bovine chronic mastitis, caused by Staphylococcus aureus, is associated with young cows
False
(old cows)
Which of the following is NOT a characteristic of Staphylococcus?
- Grow on non-enriched media
- Stable in the environment
- Cause pyogenic infections
- Commensals on mm and skin
- All of the above are characteristics of Staphylococcus
All of the above are characteristics of Staphylococcus
Which of the following is described as a Gram [+] pleomorphic non-spore forming human/animal pathogen?
- Staphylococcus
- Streptococcus
- Listeria
- Corynebacterium
Corynebacterium
What is the most common pyogenic organism in humans and several animal species?
Staphylococcus aureus
What is the leading pus-forming bacteria in dogs?
Staphylococcus pseudointermedius
Toxic Shock Syndrome toxin (TSST-1) is associated with which microorganism?
Staphylococcus

What are the hemolytic toxins associated with Staphylococcus?
alpha, beta, gamma, delta
complete hemolysis refers to ___-hemolysis
complete hemolysis refers to β-hemolysis
What type of hemolysis is present?
β-hemolysis
The typical lesion associated with Staphylococcus is the:
abscess!
inflammatory focus in which participating cells have been destroyed by the combined effect of bacterial and inflammatory cell activity

alpha toxin from Staphylococcus aureus produces ___-hemolysis
β-hemolysis
Name the bacteria responsible for Exudative Epidermitis (Greasy Pig Disease).
What is the key virulence factor involved?

Staphylococcus hyicus
Key virulence factor: Exfoliative toxin
Name the bacteria that causes bumblefoot in gallinaceous birds
Staphylococcus aureus
Bumblefoot is a chronic pyogranulomatous process in subcutaneous tissues of the foot resulting in thick-walled swellings on one or more joints

T/F: Streptococcus is catalase positive
False.
STAPHYLOcoccus is catalase positive. Streptococcus is catalase negative, fool
The most pathogenic strains of Streptococcus produce ___-hemolysis
The most pathogenic strains of Streptococcus produce β-hemolysis

The capsule of *Streptococcus *is composed of ___________
hyaluronic acid (HA)
HA is a constituent of mammalian connective tissue
M-protein, one of the major virulence factors in Streptococcus, is anti-phagocytic by binding __________ and ____________
M-protein, one of the major virulence factors in Streptococcus, is anti-phagocytic by binding fibrinogen and Factor H
Which Streptococcus species is responsible for genital & mastitic infections and STRANGLES in horses?
Streptococcus equi subsp. equi
Strangles is a highly contagious febrile rhinopharyngitis involving abscessation of regional lymph nodes
Widespread abscess formation with systemic manifestations associated with Strangles are referred to as:
Bastard Strangles
T/F: Staphylococcus agalactiae is an extremely important causative agent of mastitis
False
Streptococcus agalactiae is an extremely important causative agent of mastitis
Not Staphylococcus
What is the leading cause of pneumonia, septicemia, and meningitis in primates?
Streptococcus pneumoniae
You are presented with a five-year-old cocker spaniel with a history of persistent pyoderma. You collect samples from the edge of the lesion and upon microscopic examination observe Gram positive coccoid bacteria. As part of your differential diagnosis in this case you should have:
- Streptococcus canis
- Staphylococcus aureus
- Staphylococcus pseudointermedius
- All of the above
- None of the above
All of the above
All of the agents can cause pyoderma, all can be found in a dog, and all are Gram-positive
You are presented with a five-year-old cocker spaniel with a history of persistent pyoderma. You collect samples from the edge of the lesion and upon microscopic examination observe Gram positive coccoid bacteria, and upon isolation and biochemical characterization the isolate is catalase positive. The most likely agent in this case is:
- Staphylococcus hyicus
- Staphylococcus aureus
- Staphylococcus pseudointermedius
- Streptococcus canis
Staphylococcus pseudointermedius
- S. hyicus is mostly found in pigs*
- S. canis is catalase negative*









































